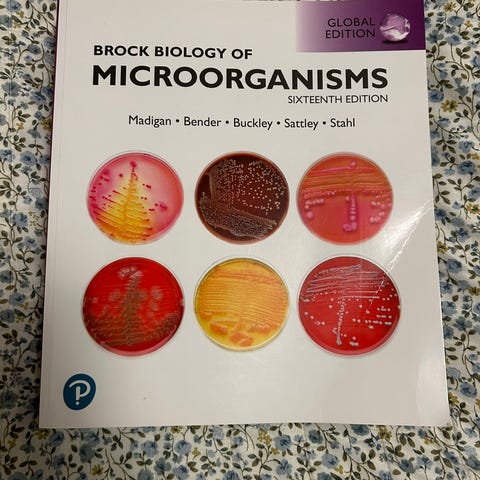

Bildegalleri
(1/5)
Brock Biology of Microorganisms
Solgt
Til salgs
250 kr
Beskrivelse av varen
Tilstand: Pent brukt - I god stand
Emne: Biologi
Pent brukt Brock Biology of Microorgansms (14. edition).
Kjøpt ny, ingen markeringen bortsett fra noen sider med blyant i margen (se bilde).
Du får med tilgang til internett materiell «Mastering Biology». Tar ikke ekstra for denne, den følger med. Tror ikke den er brukt, og er noen år gammel så kan ikke garantere at den funker - derfor den bare følger med ☺️
NB: Knappen for å vise hele beskrivelsen har kun en visuell effekt.
Brukerprofil

Du må være logget inn for å se brukerprofiler og sende meldinger.
Logg innAnnonsens metadata
Sist endret: 14.1.2026 kl. 14:58 ・ FINN-kode: 415814194












